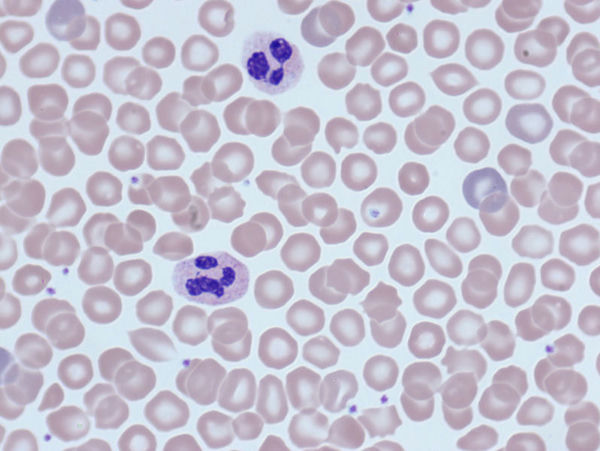
10.jpg

明美研究级生物显微镜助力骨髓细胞观察
在医学研究领域,骨髓细胞的观察与分析对于疾病的诊断、治疗及预后评估至关重要。近期,明美生物显微镜ML51-N安装于湖南省肿瘤医院病理科,为骨髓细胞观察与分析提供有力支持。
骨髓细胞观察是血液系统疾病诊断的重要手段之一。通过镜检骨髓细胞的形态、数量和比例,医生可以了解骨髓的增生情况、细胞的分化与成熟程度,以及是否存在异常细胞等信息。这些信息对于贫血、白血病等血液系统疾病的研究诊断、分期、预后评估以及治疗效果的监测具有重要意义。
借助生物显微镜ML51-N,可以看到骨髓细胞的细微结构,识别骨髓细胞的特征,为疾病研究诊断提供判断依据。生物显微镜ML51-N采用无限远光学独立消色差设计,成像清晰,色彩真实。配备超宽视野目镜和平场半复消色差物镜,视野平坦清晰,提供高信噪比、高对比度的显微成像。

搭配2000万高像素显微镜相机MDX10,精确还原样品的精细结构和真实色彩,为骨髓细胞的观察提供高质量的图像数据。MDX10采用USB3.0数据传输接口,即使在2000全分辨率下也能流畅运行,为快速获取分析骨髓细胞信息提供有力支持。
生物显微镜ML51-N还采用长寿命LED科勒照明和光强管理器,提供稳定、均匀的照明效果,并可根据不同倍率物镜调节照明强度,确保观察过程中亮度一致。此外还可扩展升级荧光、相衬、暗场等观察效果,潜力巨大。广泛应用于生物研究、医学检验、疾病预防、教学科研等领域。
免责声明
本站无法鉴别所上传图片、字体或文字内容的版权,如无意中侵犯了哪个权利人的知识产权,请来信或来电告之,本站将立即予以删除,谢谢。